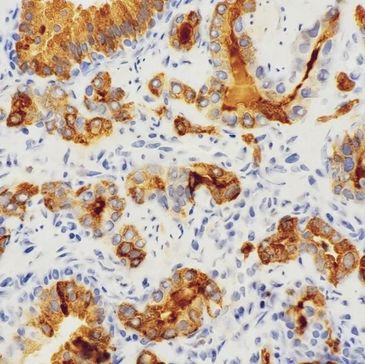

CanTar® PreClinical Services

CanTar® The Black Page®
Target ID & Characterization
Target ID & Characterization
CanTar Black Page® is a Cancer Target Outlook Report that concentrates on analyzing novel and first-in-class target biology and predicted expression utilizing publicly available databases. The report assists in Go/No-Go decision-making (Decision-Gate).
Target ID & Characterization
Target ID & Characterization
Target ID & Characterization
Early R&D Target Identification & Characterization (ETIC) includes an in-depth assessment of target expression in pharmacologic screens of representative cancer cell lines and xenograft models.

Preclinical Assay Development
Target ID & Characterization
Preclinical Assay Development
Preclinical Assay Development (PCAD) includes early pathology, technical, and professional expertise to identify and select clones of interest for testing and evaluating their sensitivity and specificity.

Optimal Assay Condition
Characterization of Biomarker
Preclinical Assay Development
Pre-Clinical Optimal Assay Condition (AOPT) service includes Pathologist Expert Advice on Optimal Assay Conditions for Target Discovery.

Characterization of Biomarker
Characterization of Biomarker
Characterization of Biomarker
Pre-Clinical Characterization of Biomarker (BCHZ) includes H-SCORE and ZWMS-SCORE® assessment for low and ultra-low expressors. Manual and Digital Image Analysis (DIA)-based semi-quantitative and quantitative target expression phenotyping for Immunohistochemistry.

Biomarker Prevalence Studies
Characterization of Biomarker
Characterization of Biomarker
Pre-Clinical Biomarker Prevalence Studies (BPREV) include ZWMS-PREV SCORE® and HeatMap for cancer cell line xenograft models and human cancer tissues.
CanTar® Discover For Pharma: Cutting-edge Translational Pathology and Target Discovery Services for Pharmaceutical and Biotech companies. All Rights Reserved. Copyright © 2026
This website uses cookies.
We use cookies to analyze website traffic and optimize your website experience. By accepting our use of cookies, your data will be aggregated with all other user data.